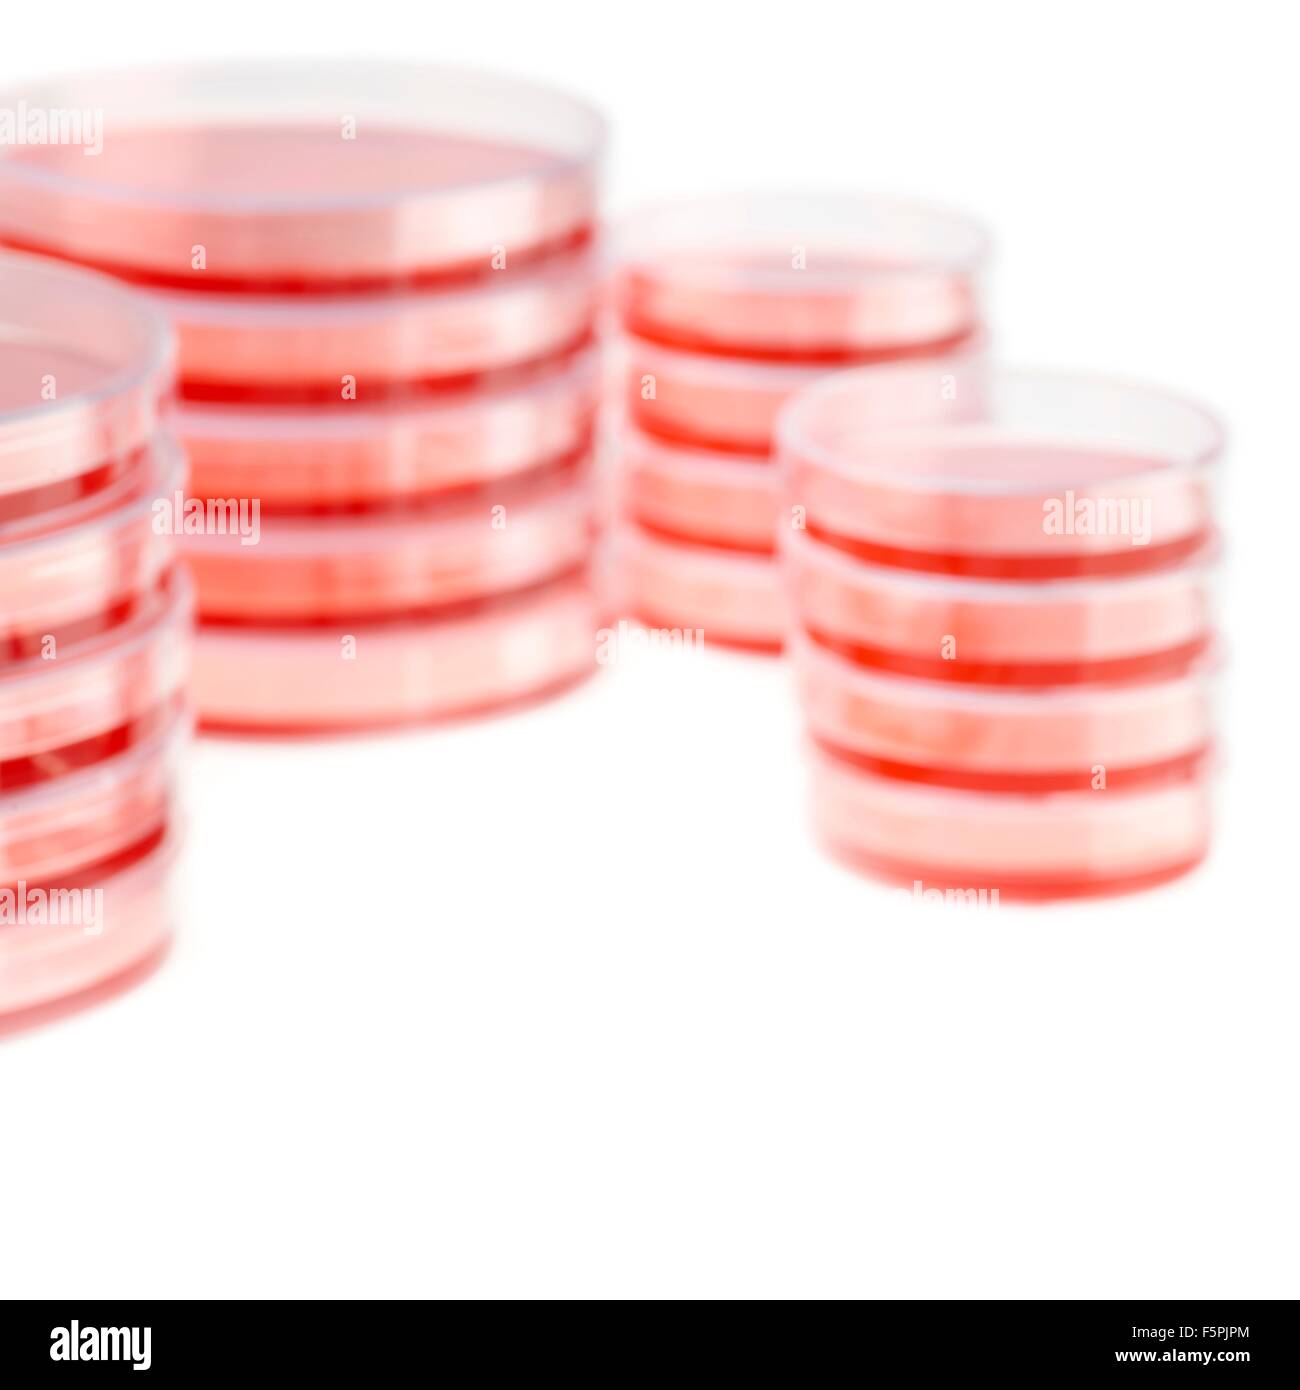
Boîtes de Pétri sur un fond blanc. Banque D'Images
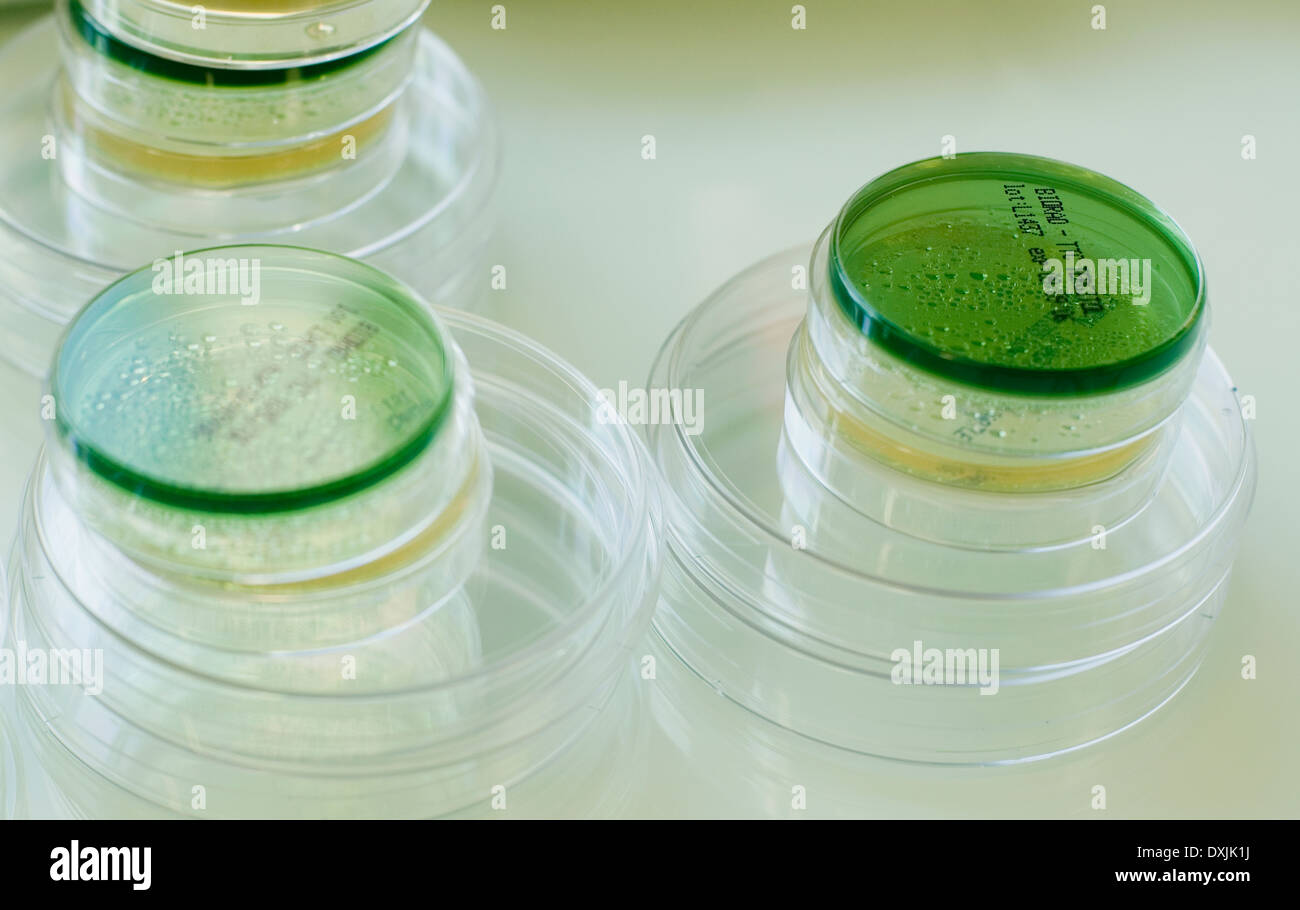
Boîtes de Pétri Banque D'Images
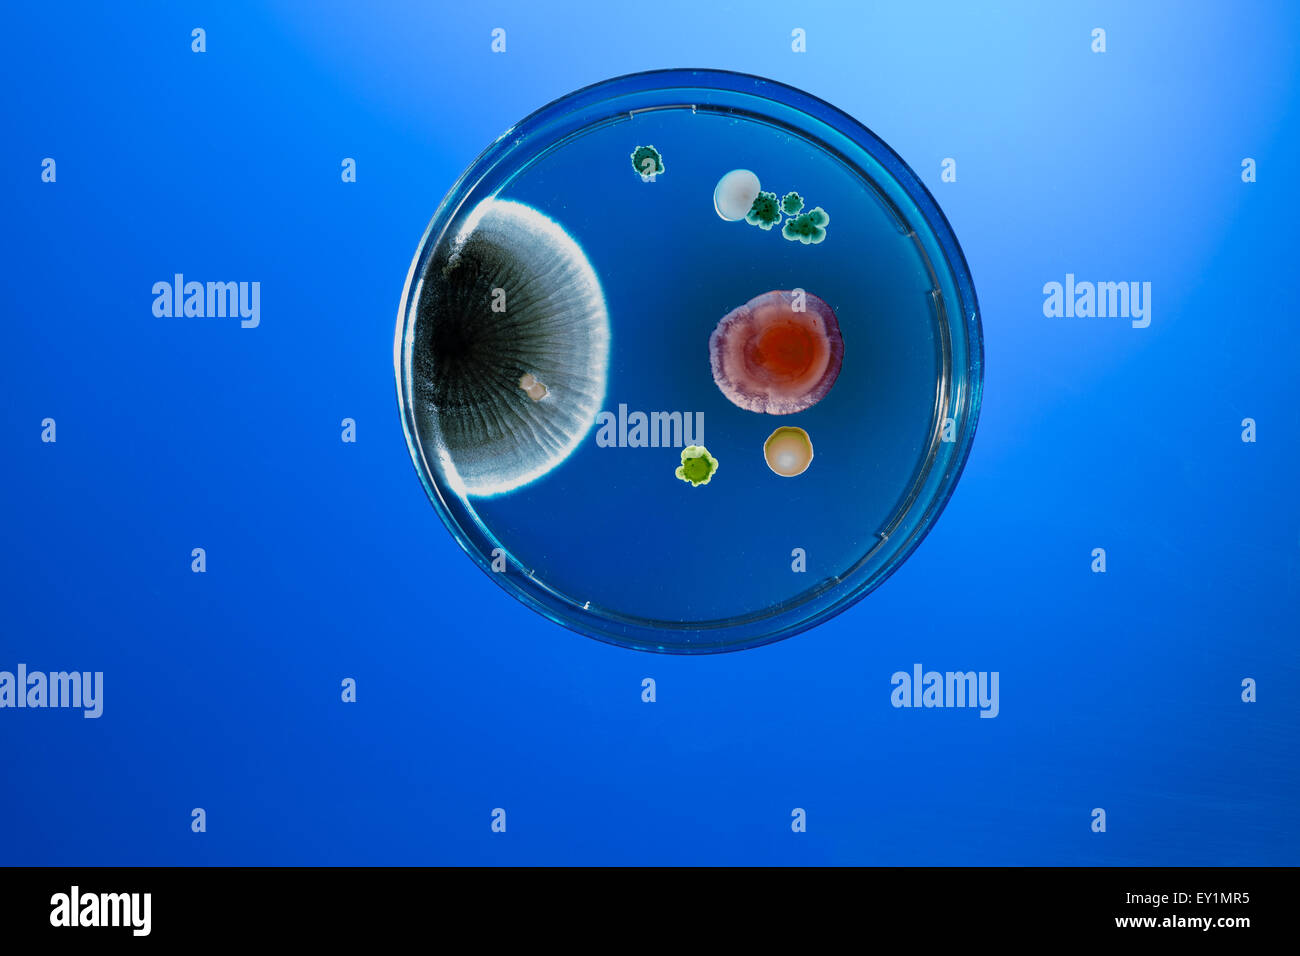
Boîtes de Pétri Banque D'Images
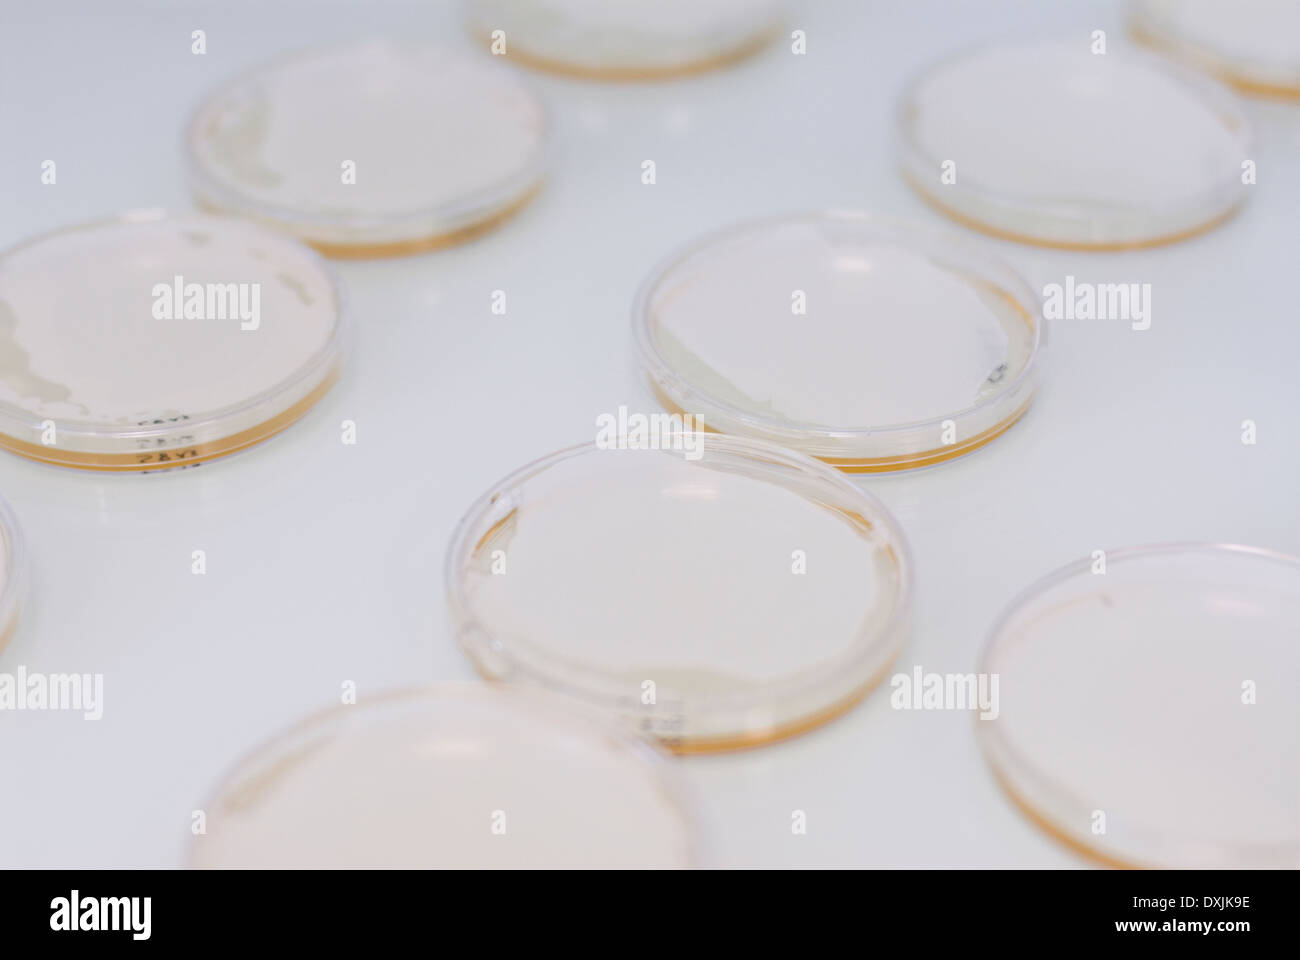
Boîtes de Pétri Banque D'Images

Les mets Photos Stock & Des Images
(527,394)Filtres rapides :
Les mets Photos Stock & Des Images

RF2GKY8YN–Des plats satellites sont servis devant les bâtiments de l'Esslemont Avenue, Aberdeen, Écosse, Royaume-Uni

RF2CE1MC1–Plusieurs plats de télévision par satellite fixés à l'édifice de l'époque 1890 à Arnold Circus, est de Londres.

RMM5PY6W–Une femme en robe période vaisselle lave-mains à un événement de reconstitution de la révolution américaine à Huntington Beach Californie USA

RMC3XXDB–Moyen Orient Egypte alimentaire les aliments traditionnels haricots tomates concombre hoummos pains

RMBBMDRM–L'Australie, Territoire du Nord. Les réflecteurs solaires qui donne du pouvoir pour le peuple d'Hermannasburg dans le nord du territoire.

RMF5MMYN–Pétri et autre biiological les échantillons dans un réfrigérateur d'un laboratoire de biotechnologie

RMRA4EW1–Plaques en plastique en plastique jetables, vaisselle, plats, les déchets plastiques, des assiettes à soupe, blanc

RMDM09DJ–Le kimchi et autres plats côté coréen exposés à la vente au marché traditionnel - Séoul, Corée du Sud

RMB5050H–De nombreuses paraboles fixées sur un balcon de l'immeuble construit comme le logement social à Pallasstrasse à Schoneberg Berlin

RMECKYCN–Scholey House, sur la succession, Winstanley adjacent à Clapham Junction station, et géré par le Conseil de Wandsworth

RMBY1MJ1–Serveurs recueillir salis au cours d'une célébration de mariage bédouin traditionnel. El Tur, péninsule du Sinaï, Égypte

RMBAM1B4–Tìpico Platon sushi de la Gastronomía de Japón Sushi plats traditionnels de la cuisine japonaise

RMB4J4XK–Les dispositifs de communications éclairées la nuit sur le dessus de la BT Tower à Birmingham UK

RF2GKY95B–Des plats satellites sont servis devant les bâtiments de l'Esslemont Avenue, Aberdeen, Écosse, Royaume-Uni

RM2KDT7XT–Vaisselle sale non lavée dans l'évier avec un panneau "garder propre gens adorables". thème - cuisine commune, espace commun.

RMM5PY6J–Une femme en robe période vaisselle lave-mains à un événement de reconstitution de la révolution américaine à Huntington Beach Californie USA

RMBX28BK–Une femme de race blanche lave la vaisselle à la main dans un dissipateur en aluminium. Libre d'une partie du corps et bras-main. USA

RMCRE20H–Publicité en anglais, des plats traditionnels islandais, Reykjavik, Islande, Scandinavie, Europe du Nord, Europe

RMDM09TC–Le kimchi et autres plats côté coréen exposés à la vente au marché traditionnel - Séoul, Corée du Sud

RMBBYPC2–Rangées de chaînes tv sur 2 plats de deux terrasses de logements sociaux à ballymena le comté d'Antrim en Irlande du Nord uk

RMB4YCK0–De nombreuses paraboles fixées sur un balcon de l'immeuble construit comme le logement social à Pallasstrasse à Schoneberg Berlin

RMBY1MJT–Serveurs recueillir salis au cours d'une célébration de mariage bédouin traditionnel. El Tur, péninsule du Sinaï, Égypte

RMBAM0DT–Tìpico Platon sushi de la Gastronomía de Japón Sushi plats traditionnels de la cuisine japonaise

RMAN7TRG–Près de Mijas Costa del Sol Malaga Province Espagne mât d'antenne et des plats de la Communication